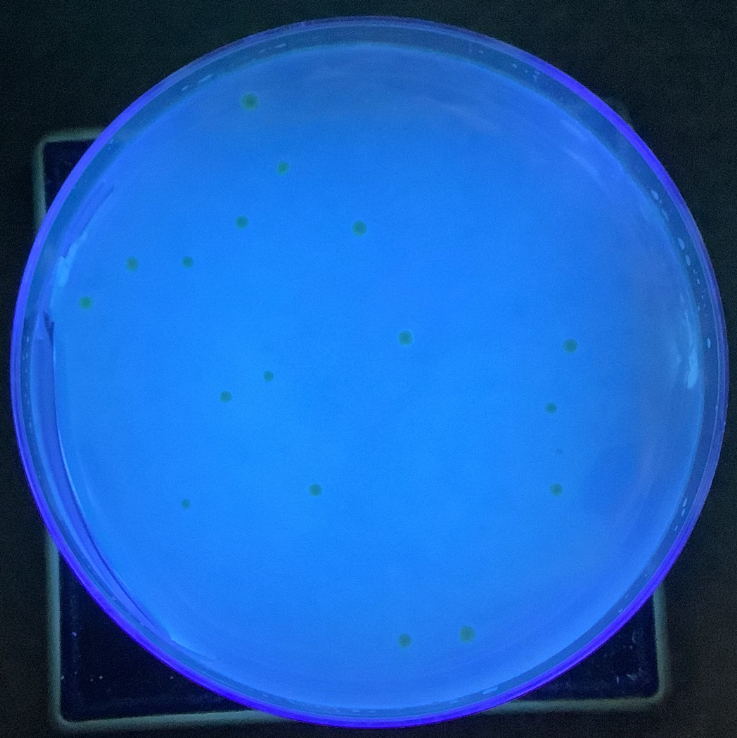

- 学校紹介
- 学校生活
- 教育内容
- 洛北SSH
- 洛北SSH事業
- 年間活動一覧
- お知らせ
- 授業内の取組
- 文理探究
- 課題探究Ⅰ
- 課題探究Ⅱ
- SHOOT Lab
- サイエンスチャレンジ
- サイエンス部
- コンテスト・学会発表
- 校外連携
- 洛北SSHだより
- 成果物(教材・資料等)
- 卒業生メッセージ
- 研究開発実施報告書
- 研究活動報告集(課題研究)
- Annual Report on Researcn Activities Abstracts in English
- 平成30年度以前の取り組み
- 在校生へ
- 中学生の方へ
- 卒業生の方へ
- 学校紹介
- 学校生活
- 教育内容
- 在校生へ
- 小学生の方へ
〒606-0851 京都市左京区下鴨梅ノ木町59 / TEL:075-781-0020(8:30~17:00)
土、日、祝日、業務休止日(8月10日~8月16日、12月28日~1月4日)を除く
土、日、祝日、業務休止日(8月10日~8月16日、12月28日~1月4日)を除く
- HOME
- >
- 教育内容
- >
- 特色ある取組
- >
- 令和7年度 サタデープロジェクト
- >
第5回 サタデープロジェクト
2026年02月06日
1月31日(土)に第5回サタデープロジェクトを実施しました。今回もたくさんの企画を実施することができました。各プロジェクトの様子をご紹介します。















「光」について実験を通して学ぼう【校外】
京都大学宇治キャンパス工学研究科を訪問しました。齋藤教授による放射線の仕組みや研究されている内容についての講義を受けたり、学部生・院生による光についての様々な実験(分光実験、混合実験、レーザー光の波長測定等)を行いました。最後に実際に研究で使用されているイオンビーム加速器施設を見学しました。普段では経験することのできない貴重な体験ができました。

心臓のつくりを観察しよう!
ヒトの心臓は、一生の間、一瞬も休まずに約30億回も拍動するそうです。そんな心臓がどのようなつくりになっているのか、ヒトとほぼ同じ大きさ(250~300g)だと言われるブタの心臓(ハツとして食用に販売されているもの)を使って観察してみました。分厚い筋肉や逆流を防ぐ弁の構造、心臓から出ている大動脈などをじっくり観察しました。予想以上に複雑な構造に驚き、その重要性を再確認する貴重な体験になりました。

エッシャーの絵を描こう
エッシャーの絵のいくつかはテセレーションと呼ばれ、数学的な考察が可能です。今回はテセレーションを用いた作品づくりのために、対称性についての講義や図形の変形のしかたの説明をしたあと、実際に作品を作りました。専用のwebサイトを参考にしながら、自作の模様をコピー機で増やして並べました。全員がきれいな作品がを作ることができて、最後にそれぞれの作品がもつ対称性がどんな分類になるか(p2, p3, p3m)を解説しました。

梅干しから塩を取りだしてみよう
梅干しは塩分を多く含む食べ物の一つです。その梅干しから真っ白な塩を取り出すことに挑戦しました。これまでの理科の学習で学んできたことを活かしながら、4人ずつ相談しながら試行錯誤を重ねました。なかなか簡単には取り出すことができず苦戦したところもありましたが、なんとか塩を取り出すところまで行けました。解決策が予想していなかった方法で驚いた人も多かったようです。学年、クラスを超えて初めて話す相手とも協力しながら課題解決に取り組め、いい機会だったと思います。


だれかのためのデザイン
今回は、4回連続講座の最終回でした。最初に、発表について、講師の平野氏からポイントと大切にしたいことについて講義をいただき、その後、グループ内調整の時間をとって、互いに発表しました。それぞれがテーマに据えた困りごとは、「傘のイシヅキのすりへり」、「スマホの画面の汚れ落とし」、「机からシャーペンを落としても芯を折らないようにするには」、「煩雑になるコードを整理したい」でした。テーマに基づき、困りごと解決するデザインを3D CADでデザインし、3Dプリントして、実際に使い、活動で得た新たな気づきについて発表をしました。それぞれ、発表のよいところがあり、まるで、企業のプロダクトデザインのプレゼンを見ているようでした。ここで得たスキルや正課を、様々な場面でどんどん活用していってほしいです。



万葉集で恋愛診断
万葉集には恋愛の和歌が多く収録されています。その中から1人1首を担当して、心理テストや若者の間で流行している○○診断をヒントにした「万葉集恋愛診断カード」を作ってもらいました。「この和歌を選んだあなたはこんな恋愛をするタイプ!」というものです。歌意をふまえて作ったので、信憑性は非常に高い...かもしれません。「いつもと違う視点から歌意を読み取ることで、作者の気持ちが分かった気がする」「恋愛をするときの気持ちは今も昔もあまり変わらないのだと思った」など、和歌を身近に感じられるよい機会になりました。


原書で読むYuval Noah Harariの世界
今年1年間で、上記著者の代表作品を講読してきました。今回は最新作であるNexus - A Brief History o Information Networks from the Stine Age to AI から抜粋して、2016 年にミャンマーで起こった反ロヒンギャ民族浄化の社会運動をソーシャルメディアが扇動した事象を例にとって、現代社会での情報を誰が、どのように管理するのかということにフォーカスし、人類とAIが直面する問題について理解を進めることが出来ました。

仕事とお金のミライとリアルを考える時間
「仕事とお金のミライとリアルを考える時間」では、「やりたいことの見つけ方」について、私自身の体験を交えながら具体例を用いて講義を行いました。あわせて、ゲームクリエーターやサッカーのクラブチームを立ち上げた人、画家、SEなど、さまざまな進路を選んだ友人の事例を紹介し、決断の仕方や長所の生かし方を通して、将来の職業選択のヒントを示しました。 後半では、やりたいことを実現するために必要となるお金や、資産運用の基礎について解説しました。講義後には、「社会について学ぶ良い機会になった」「自分の長所を生かした仕事選びや将来について考えるきっかけになった」「不安はあるが、まずはいろいろなことに挑戦したいと思った」など、多くの前向きな意見が寄せられました。

キッチンサイエンス
今年度最後のまとめとして、「ノンアレルギーパン」「栄養満点アレルゲンフリーのパン」「小麦アレルギーでもダイエット中の人でも食べられるパン」の3テーマで、前回の実験の結果をもとにグループごとにディスカッションを行い、滋賀大学 加納研究室の学生の皆さんの前で取組の成果発表をしました。 仮説通りにはいかなかったものの、新しい食感が生まれたり、次に挑戦したみたいレシピを考えたり、改めて料理は科学であること、まだまだたくさんの謎があることを実感できたようです。

伏見桃山でフィールドワーク【校外】
JR桃山駅→大手筋商店街→濠川・宇治川派流遊歩道→竜馬・おりょう像→寺田屋→観月橋→奈良街道という伏見城の城下町をテーマとしたフィールドワークを行いました。
大変寒い中でしたが、地図を片手に2時間近く歩きました。JR桃山駅周辺では、複数の地図を基に、堀の痕跡や商人地や大名屋敷であったことを示す地名を確認しました。大手筋商店街では、丘陵地の坂を下っていることを体感するとともに、元祖銀座の石碑や豊富な地下水が流れいることを示す手がかりを探しました。遊歩道では、濠川が宇治川に合流する場所に伏見港公園があり、かつては水運の要衝であったことを理解しました。また寺田屋(旅籠)が、かつて港湾地域で働く人たちの寝泊まりする宿場であったことも確認しました。
その後、一次解散を行い、希望者のみで観月橋を渡り、国道24号線から外れて豊臣秀吉が太閤堤を築き、その上に通した奈良街道の街道筋を歩きました。


第4回 サタデープロジェクト
2025年12月19日
12月13日(土)に第4回サタデープロジェクトを実施しました。今回もたくさんの企画を実施することができました。各プロジェクトの様子をご紹介します。











細胞生物学で学ぶスキンケア
毎日何気なく使っている化粧水や日焼け止めについて、「どのように肌を守っているのだろう?」という素朴な疑問を出発点に、肌の構造や紫外線の影響について生物学の視点から探ってみました。
本講座では、講義だけでなく、UVビーズを使った実験も実施。紫外線がどれほど強力なのか、そして日焼け止めやアームカバー、サングラスといった対策がどれほど効果的なのかを、目で見て確かめることができました。
参加した生徒からは、「実験を通して日焼け止めの効果がよく分かった」「化粧品の成分やしくみについて 理解が深まった」といった感想が多く聞かれ、興味をもって積極的に質問する姿も見られました。
こうした学びを通して、生物の知識が日常生活とつながり、身近なことを科学的に考えるきっかけになったと感じています。普段のスキンケアに、ちょっとした科学の視点を加えてみると、毎日のスキンケアがもっと面白くなるかもしれません。
虚数単位iをつくる
数学Ⅱで学習する虚数単位iが行列を用いて表せることを学習しました。前提知識は実数の四則計算のみと銘打っていたので、そこから出発し、行列の和や積を定義して行列の世界の四則演算を考え、行列の世界での0や1を探しました。そのあと、「2乗したらー1になる」という虚数単位の定義をヒントに、これを満たす行列を探しました。方程式を作ってそれを解こうとする人、数値を1つずつ当てはめて探す人などそれぞれの方法で虚数単位となる行列を探し、実際に見つけることができました。最後には複素数の図形的な性質にも触れ、複素数の利点について考えました。

野菜をもっと知ろう
普段何気なく食べている野菜について学習しました。はじめに、人気の野菜ランキングを予想し、実際にスーパーで購入した野菜を用いて、各班でプレゼンテーションを行いました。その後、人気野菜ランキング上位であるトマト・キャベツ・ダイコンについて、原産地や地域ごとのタイプの違い、食文化、さらには研究に関する話まで、幅広い内容を学びました。活動後には、「野菜について深く知ることができて良かった」「今日学んだことを意識しながら野菜売り場を見てみたい」といった前向きな感想が多く聞かれました。今回の学習を通して、普段何気なく目にしている身近な野菜を、意識して捉えるきっかけになったのではないでしょうか。

原子物理学を用いて放射線を「みて」みよう!~霧箱の観察~
放射線にはα線、β線などがあります。そんな目に見えない放射線を「みえる」ようにするのが『霧箱』です。霧箱の中では、α線やβ線が幻想的に映し出されます。そう、まるで飛行機雲のように。
ペルチェ素子を用いた霧箱では、放射線の種類や透過性について学びました。ドライアイスを用いた大型霧箱では、線源が無くても放射線が観測できる、つまり自然放射線の存在を観察しました。参加者からは、「こんなに放射線が見えると思っていなかった」「空気や食物からも放射線が出ていることに驚いた」などの感想が聞かれ、放射線についての正しい知識と、観察のしくみについて理解が深まったようです。

だれかのためのデザイン
3回目となる今回は、これまでの取組状況の発表から始まりました。それぞれのデザインのプリント品を使って、状況や使い方、今後どんな風にしていきたいかを各グループから発表していきました。交流をしながら、自分たちのデザインの価格設定なども考え、実際に困りゴトを解決するプロダクトとしてのイメージを固めました。今後は、次回の最終発表に向けて、デザインの推敲、プリントによる使用テストを行っていきます。



キッチンサイエンス
2回目となるキッチンサイエンスでは、人々の健康と食およびサイエンスを意識して、食「小麦アレルギーでもダイエット中の人でも食べれるパン」、「米粉をつかってもちもちのノンアレルギーパン」、「栄養満点アレルゲンフリーのパン」、「糖尿病の人も安心して食べやすい糖質置き換えパン」など、グループで設定した仮説を検証するための実験を行いました。完成したパンは、色、弾力、味や舌触りなどの要素に注目しながら評価をしました。次回は、それぞれの結果をまとめ、発表する予定です。

東山でフィールドワーク【校外】
蹴上駅→ねじりまんぽ→南禅寺→哲学の道→白川・琵琶湖疎水交差点→銀閣寺という東山をメインとしたフィールドワークを行いました。
快晴の一日で、終わりかけの紅葉を楽しみつつ、地図を片手に1時間近く歩きました。ねじりまんぽや南禅寺では蹴上インクラインや琵琶湖疎水の役割を確認し、哲学の道では、右手の断層によってできた崖を感じながら歩きました。白川・琵琶湖疎水交差点では,逆サイフォンと呼ばれる仕組みを利用した立体交差を感じました。銀閣寺では、「庭にある枯山水の砂はどこから来ているのか?石畳には何石が使われているのか?」ということについて地図を用いて考え、東山の微地形の成り立ちを理解し、足利義政がなぜこの地に銀閣を建てたのか仮説を立てました。


「原書で読む Yuval Noah Harari の世界」第2回 Homo Deus を読む
3回シリーズの第2回目。世界的な大ベストセラーとなっている Yval Noah Harari の著作から、今回は Homo Deus の一部を講読し、その思想性の基盤となる英語表現の理解及び鑑賞を通じて、より高次の読解力の養成の一助とする。
次回は1月に最新刊のNexus を講読する予定。

宮大工を知る!建築体験ワークショップ
首里城の再建などにも携わっている京都の宮大工集団である匠弘堂の皆さんにお越しいただき、講義とワークショップを実施しました。横川社長による講義では、首里城の屋根の修理や今宮神社の大鳥居の修理の話や、200~300年続く建造物をつくる心意気がとても大切であるというお話を聞きました。
後半では、蟇股(かえるまた)を描くワークショップでは、国宝の長久寺の蟇股(社寺建築などにみられる梁(はり)や桁(けた)の上に置かれる建物構造上必要な支柱に装飾が施されたもの)のトレーシングペーパーで写し取りにチャレンジしたり、木材のかんな掛けにチャレンジしたりしました。生徒たちは木材の香りや表面のツルツル感にとても感動している様子でした。

第3回 サタデープロジェクト
2025年10月17日
10月11日(土)に第3回サタデープロジェクトを実施しました。今回もたくさんの企画を実施することができました。各プロジェクトの様子をご紹介します。















バイオテクノロジー実験講座「光る酵母菌をつくろう!」
生物実験室では、バイオテクノロジー実験講座として「遺伝子組換え実験」を行いました。遺伝子組み換え技術に関する簡単な講義の後、山口大学大学院医学系研究科の赤田研究室で配布されている実験キットを用いて、緑色蛍光タンパク質(GFP)の遺伝子をパン酵母に導入し、「緑に光る酵母菌」を作製する実験を行いました。この手の実験は大腸菌を用いることが多いのですが、今回はパン酵母。ほんのりパンの香りがする中での実験です。
実際に行う操作は驚くほど単純で、ちょっと拍子抜けしてしまったかもしれませんが、それでもよくわからなかった「遺伝子組換え」について、その技術の一端に触れ、安全性などについて考えることができました。

草木染めを体験しよう!
ログウッドから抽出できる染料を使って草木染を行いました。はじめに、媒染液に含まれる金属イオンや液性を変えたり、絹やウール、綿など染める布の種類を変えたりすることで、発色が変わることを確かめました。その後、綿のハンカチやウールのコースターを染める活動を行いました。「空色」「灰色」「ピンク」など目標とする好きな色を班で話し合い、媒染液や染料の濃度を工夫して染色に挑戦しました。思い通りの色に染まらない班もありましたが、「自分達で方法を考え、染めるのは理解も深まり楽しかった」という前向きな感想が聞けました。草木染を通して、科学的に考え試行錯誤する楽しさを体験できたようです。


外来生物を知ろう
情報,経済,物流などにおけるグローバル化が叫ばれるようになって久しくなります。実はこれらの波は動物や植物の世界にも押し寄せています。毎日,普通に外国人の姿を見かけるように,気づけば私たちに周りは外来種でいっぱいです。今回は,植物を中心に,そんな外来種の定義や色々な分け方,種類などを教室で学習した後,フィールドへ出て実際の外来植物を採集し同定の後,原産地などを調べました。校内をぐるっと回り,校外は北泉通りまでの間で,あっという間に30種類以上の外来植物が集まりました。


実験結果から考察しよう
医師であり、京都大学理学研究科博士課程2年生でもある河村恒次氏を講師に迎え、「大学への生物 〜どう考え、どう覚えるか〜」をテーマに、実験考察講座を実施しました。
前半では、実験データをもとに複数の仮説を立て、それに基づいて次の実験を計画するトレーニングを体験しました。生徒たちは積極的に意見を交わし、仮説の立て方や検証方法について活発な議論が展開されました。
後半では、理科の知識を「つなげて覚える」ことの重要性と、その具体的な実践方法について学びました。AI時代においても、深く考えるためには関連づけた記憶が不可欠であることを再認識する内容でした。
生徒たちにとって、大学レベルの思考に触れる貴重な機会となり、学びへの意欲が一層高まった様子がうかがえました。


だれかのためのデザイン
連続講座の2回目である今回は、前回設定した「困りゴト」解決のためのデザインを開始しました。3D CADソフトの「Fusion」を使い、思い思いのデザインを行いました。一部のデザインは、その場で3Dプリントして、実際の形も確かめました。これからは、3D CAD→プリント・試行→アイデアだしの繰り返しでより良いデザインを行っていきます。最終的にどんな作品に仕上がるのか、楽しみです。



キッチンサイエンス
毎年「料理は原理を知るともっと楽しく上手に」をテーマに条件を変えながら、科学的に美味しく料理をつくる通年の企画です。パン教室を開いている小久保先生をお招きして、美味しい白パン&チーズパンを作りました。また、発酵、混ぜる順番、こね方、温度、材料などレシピにはそれぞれ科学的な意味があることも学んでもらいました。そこから、よりよいパンになるよう、材料や手順について科学的に考えながら、新しいアイデアをグループで考えてもらいました。次回は、立てた計画をもとにオリジナルのパンを作成してもらいます。

ZUMBAを踊ろう
京都大学大学院を修了後、企業で約10年間にわたり植物研究に携わり、その後ズンバインストラクターへと転身されたという異色の経歴を持つ松井氏を講師に迎え、ZUMBAを体験しました。
前半では、参加者同士の自己紹介や松井氏の経歴紹介を通して、会場の雰囲気が和やかに打ち解けました。
後半では、コロンビア発祥のフィットネスダンス「ZUMBA」を実際に体験。多くの方にとって初めての挑戦でしたが、
「ダンスが苦手で少し不安だったが、間違えても良いという言葉に安心して楽しめた」
「身体を動かすと開放感があり、とても気持ちよかった」
「ぜひ来年も参加したい」
など、前向きな感想が多数寄せられました。

地理オリンピックの過去問にチャレンジ
国際地理オリンピックの日本代表を選出する日本選手権の1次試験の過去問に挑戦しました。1次試験はMMT(マルチメディアテスト)と呼ばれ、タブレットやパソコンを用いて4択の問題に解答します。それぞれの問題には図表や写真、グラフ、ときには動画が用意されており、それらをよく見ながら1分で各問題に解答する必要があります。もう少しで答えが出る問題がタイムオーバーで終わってしまったときの「あ~~」という叫びが印象的でした。大会参加費は無料で自宅でも受験できるので参加者を募集しています。

古着をまったく違う製品に?ー古着活用アイデアワークショップー
京都でアパレルショップを運営する株式会社ヒューマンフォーラムさんにより、たくさんの古着を持ってきていただき、捨てられるはずのモノにあらたな命を吹き込むアイデアを皆で出し、カタチにしていくワークショップを実施しました。
グループで出てきたたくさんのアイデアから、古着の色や部品を活かしたオリジナルの品を考え、帽子やキーケース、シュシュ、などとても素敵なものを皆作っていました。0から新しいモノを作ることは難しいけれど、皆で捨てられてしまうモノを素敵なモノに生まれ変わらせることができてとても楽しく、ワクワクした!もっとやりたい!という感想が多かったです。

マッスル英会話
マッスル英会話では、オール・イングリッシュの環境でウエイトトレーニングを行いました。はじめの方は、「トレーニングルームに入った瞬間、いきなり英語が使われていて緊張した」という声もありましたが、身体を動かし、試行錯誤しながらも積極的にコミュニケーションをとる様子が見られました。
「普段から英語を使わない自分にとって、とても新鮮な感じでした。」
「普通にしんどかったけど、筋トレに関する英語や教え方などを楽しく学んだ。」
「これからも(日本語でも)友達をはげますような言葉をかけていきたい。」
等の感想を寄せてくれました。頭も身体もヘトヘトの様子でしたが、最後までやり遂げた達成感に満ちた表情が印象的でした!
第2回 サタデープロジェクト
2025年09月19日
9月13日(土)に第2回サタデープロジェクトを実施しました。たくさんの生徒たちが主体的に取り組む様子が見られました。各プロジェクトの様子をご紹介します。



















水の中で起こる不思議な化学の世界を見てみよう!
9月13日(土)第2回サタデープロジェクトにおいて「水の中でおこる不思議な化学の世界を見てみよう」を実施しました。ケミカルガーデンやカラフルカプセルの作成および試験管内で雪を降らそう、という3つの実験を行い、水の中でおこるカラフルな化学現象を体験しました。18名の参加者からは「ゆったりと長い時間の観察で変化していく様子を楽しめた」、「化学を身近に感じて楽しく学ぶことができた」などの感想が寄せられ、実験の様子を写真や動画に残していました。

廃材から色が生まれる?科学とアートの実験室
京都の老舗画材店「画箋堂」との特別コラボレーション企画に約30名の生徒が参加しました。普段はそのまま捨ててしまう、コーヒーかすや野菜の皮など、身近な素材を事前に天日干しして持ってきてもらい、自由に絵を描き最後に発表を行う内容でした。 そもそも絵具の中には何が入っているのかを考えたり、持ってきた材料を乳鉢やハサミを使ってなるべく細かくしたり、ミルで粉砕したり、茶色のサツマイモの皮をメディウム(顔料と混ぜる溶剤)で混ぜたらなぜか青色になったり。楽しみながら、色々な気づきや驚きがたくさん得られたワークショップになりました。


必勝法
探究活動を全面に出して「100マスゲーム」「三山くずし」「サイコロの和を13にしよう」の3つのゲームを提示して、2人ないし3人でグループになり実際に戦ってもらうなかで必勝法を考えてもらった。考えがまとまったグループは前に出て先生と戦う形をとり、そこでヒントを出したり、結構白熱した雰囲気であった。感想でも「ゲームという身近な題材の中にも数学があることが分かっておもしろかった。」「友人と実際に対戦していくうちに必勝法が見えてきて楽しかった。」「この問題だけでなく、いろんなところで、与えられた課題に答えを見いだしていくにはどうすればいいかが分かり、ためになった」など、概ね好評でした。


キャベツのクローンを作る~植物組織培養~
キャベツを培養してクローンを作る実験を行いました。クローンを作るには、材料の調整から殺菌、培養まで多くの工程があり、特に注意しないといけないのはカビや細菌による汚染(コンタミネーション)です。コンタミを防ぐために手や器具をその都度しっかりと殺菌しながら、作業を進めました。初めてクリーンベンチを使う人が多く、戸惑いも見られましたが、その中でも楽しみながら取り組む様子がうかがえました。うまくいけば、1-2週間したら培養した脇芽が動き出してきます。コンタミが出ないことを祈るばかりです。


だれかのためのデザイン
だれかのためのデザインは、Kyoto Makers Garageの平野氏を講師としてお招きしたデジタルを活用したモノづくりの連続講座です。この講座では、身の回りの「困りゴト」を解決するデザインを考え、形にしていきます。第1回目の今回は、「困りゴト」をみんなで共有したあと、「困りゴト」の問題点抽出、解決するためのアイデア出し、試作品作りの過程を個人・グループで行いました。今回の試作はペーパークラフトで行い、発表で互いの作品を共有しました。次回は、3D CADを中心に設計を行っていきます。それぞれの作品が形になっていくのが楽しみです。

青年海外協力隊・理数科教師の2年間
青年海外協力隊,タンザニアの人々の暮らしや学校についての体験談を聞き,そしてスワヒリ語を話す体験もしました。「挨拶文化やカリブ精神がいいなと思った。」「貧しい生活の中で身についた知恵に驚いた。」「私も将来挑戦してみたい。」「スワヒリ語のもっと難しい文法や単語の講座を楽しみにしています!」などの感想があり,良い学びの時間になったようでした。

洛北古典漫遊
今回の「洛北古典漫遊」は「文学の名残を追ふ」と題し、『源氏物語』や百人一首に登場する寺社を中心に巡りました。今回の取り組みでは、関連のある文学作品について事前に読んでもらいました。 テクストと実際の風景のつながりを体感できたものと思います。また当日は、ミッションと称してそれぞれテーマに応じた5つの写真を撮ってもらいました。単に観光地を巡るだけでなく、「古典」をテーマに焦点を絞り、発見を記録として残すことができました。普段の授業でも、今回の旅の写真が内容理解の一助となれば幸いです。










第1回 サタデープロジェクト②
2025年06月17日
3D CADを学ぼう!
この講座では、Kyoto Makers Garageの平野氏をお招きして、3D CADデザインの考え方、および、3D CADアプリ「Fusion」の基本的な使い方を学びました。3D CADアプリを使ったことのない生徒がほとんどでしたが、みんなそれぞれに3Dデザインを行うことができ、とても満足していました。引き続き、「Fusion」は使用できますので、積極的に3Dデザインにチャレンジしてほしいと思います。
世界遺産で考える
世界遺産検定の教材を使いながら世界遺産に関する探究活動をおこないました。世界遺産に詳しい生徒やそうで無い生徒も含め、様々な問いに興味を持って、楽しみながら学んでいた様子でした。中には実際に世界遺産検定に興味をもった生徒もいたようで、是非とも在学中にチャレンジしてもらいたいと思っています!
第1回 サタデープロジェクト①
2025年06月13日
トポロジー~柔らかい幾何学~
合同、相似など、中学校で習った図形の分類から発展して、同相や微分同相の考え方を学びました。合同は反転、回転、平行移動して重なるものは同じ図形と判断していましたが、同相は簡単に言うと、図形の辺や角を引っ張って伸ばしたり、縮めたり、「柔らかく」変形して重なるものを同じ図形と考えます。この同相の考え方でアルファベットやひらがなを図形とみなして分類したり、自分がかいた絵や文字で仲間探しをしたりしました。最後は「トポロメモリー」というボードゲームで同相な図形を取るゲームをして、理解を深めました。
医療画像で学ぶ身体と検出器の世界
X線撮影、X線CT、MRI、PETなどの画像と仕組み、適応などについての講義がありました。医療と技術が関係していることは皆さん知っていると思いますが、その技術の中身を把握すると、どうしてそのような検査をこのタイミングでするのか、なぜ、この人にこのような対応をしないといけないのか、といったことが理解できるようになります。そして美しいまでの科学の論理が生きている人間の体の内部を見せてくれます。人体も含め世界って本当に美しいですね。
お茶のひみつ
毎年実施しているキッチンサイエンスの講座ですが、今回は特別企画として、滋賀大学の加納圭教授と研究室の学生さんによる、「お茶のワークショップ」を行いました。緑茶は何℃でいれると美味しいのか?実際に温度を変えていれたお茶を試飲して、うま味や苦み、色の違いなどを比較したり、日本茶と紅茶の違いをクイズ形式で学んだり、世界でのお茶の呼び名を「チャ」と「テ」に分類しながらお茶の歴史的な広まり方について学んだり、楽しみながら様々な視点でお茶について考える時間になりました。
野菜の品種改良
普段食べている野菜にも多くの知恵が詰まっています。おいしくて、育てやすい野菜を作るにはどうするのか?桃太郎トマトの開発の裏話や一般的な品種改良の話、DNAを用いた選抜など、野菜の品種改良に関する講義を行いました。「普段なんとなくみていた野菜がこんなにたくさんの努力によってできていることに驚きました。」「これからスーパーや家で野菜を見るときは今日の講義を思い出してみると面白そう。」「座学だったけど意見交換が多く楽しかった。」 「今後も生物関係の企画には積極的に参加したい。」等前向きな意見が数多くありました。みな一様に普段の生活に密着している生物学を楽しいでいる様子でした。
ファンタジーの世界へようこそ
現代のマンガやアニメ、文学や映画などに咲き誇っている「ファンタジー」。でも、「ファンタジー」っていったい何だろう? ということで、言葉の定義、文学ジャンルについての解説や、実際の作品の分析などを行いました。
自分が読んだことのある作品について交流したり、文学ジャンルの分類にチャレンジしてみたり、みなさんそれぞれに興味を持って活動に参加してくれたようです。「今まで考えたことがなかったので面白かった」「作品分析から現代社会を考えるのが興味深かった」という感想を多くいただきました。文系の学問、文学研究や作品研究について、少しでも触れる機会になったならよかったと思います。ナイトミュージアム
京都国立博物館大阪・関西万博開催記念「日本、美のるつぼ」を鑑賞する夜のツアーに出かけました。生徒の感想からは「この企画に参加してみて日本や海外の芸術品について、その美しさと技術の高さに圧倒されました。」と、日本を代表する300点以上もの歴史的な美術品の数々に感動したようです。また、「日本の名品が世界からの評価を受けることでその価値が高まった」ことを知ったり、「葛飾北斎は対比を評価されており"赤富士の下には青"というような独特の綺麗さがある」と美の見方を知ったりするなど、新たな見解を発見することができたようです。ナイトミュージアムならではの、京都国立博物館の夜の美しさも堪能でき、素晴らしい体験となりました。
COPYRIGHT (C) 京都府立洛北高等学校・洛北高等学校附属中学校















 クリックで子カテゴリが表示されます。
クリックで子カテゴリが表示されます。